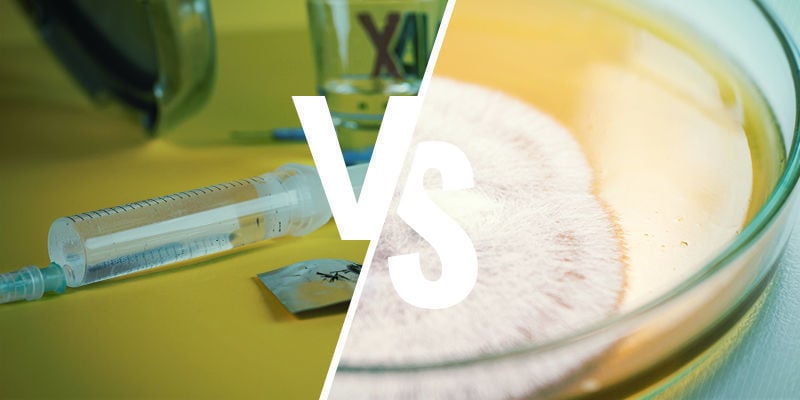

Por favor, inicie sessão para aceder à sua lista de desejos

Escolha sua ferramenta de IA favorita para obter um resumo rápido.
Existem várias formas de inocular um substrato para cultivar cogumelos mágicos. Desde culturas líquidas misteriosas até placas de Petri, pode ser difícil escolher o método mais adequado ao começar. Utilizar uma seringa de esporos é uma das opções mais simples e higiénicas — a escolha ideal para principiantes!
Cultivar os próprios cogumelos mágicos é uma experiência incrivelmente gratificante. No entanto, o processo envolve vários passos importantes, que devem ser realizados com rigor e atenção ao detalhe. O primeiro passo é inocular o substrato, seguido da germinação dos esporos. Para quem se está a iniciar, o método prático e detalhado pode ser tão desafiante quanto empolgante. Estamos aqui para tornar tudo mais acessível: descubra connosco como preparar a sua primeira seringa de esporos de cogumelos mágicos.
A seringa de esporos é um elemento fundamental para quem cultiva cogumelos mágicos em casa — é nela que se inocula o substrato escolhido. São os pequenos esporos, suspensos na solução dentro da seringa, que guardam o código genético dos cogumelos que crescerão em abundância. Misturar os esporos em água estéril, utilizando a seringa, é um dos métodos mais práticos e fiáveis para iniciar o processo de germinação destes fungos.
Utilizar uma seringa de esporos é, provavelmente, a forma mais simples e prática de garantir a limpeza no cultivo de cogumelos, sobretudo quando combinado com um fluxo laminar. Existem outros métodos de inoculação, como as culturas líquidas, que serão abordados mais à frente. De forma geral, uma seringa de esporos permite que os esporos sejam introduzidos diretamente no substrato com um risco mínimo de contaminação (desde que o processo seja feito corretamente).
Se está a começar a cultivar pela primeira vez, esta técnica é difícil de superar. É simples, fiável e acessível para principiantes. Aliás, muitos cultivadores experientes continuam a preferir este método.

Para preparares uma seringa de esporos, deves primeiro obter esporos de cogumelos mágicos. Estes podem ser adquiridos facilmente online sob a forma de impressões de esporos ou em seringas já prontas a usar.
Para minimizar o risco de contaminação, cria um ambiente o mais limpo possível e com pouca circulação de ar. O ideal é utilizar uma caixa de fluxo de ar parado ("still air box") ou um sistema de fluxo laminar. Se não for possível, recorre a uma divisão pequena com superfícies que possas desinfetar previamente com lixívia. Usar luvas e uma máscara é também aconselhável.
Embora nesta fase o risco de contaminação não seja o mais elevado, compensa sempre adotar alguns cuidados. Afinal, o cultivo de cogumelos exige tempo e dedicação, e não há nada pior do que veres o teu trabalho estragado por bolor passado dois meses!
Todo o material necessário indicado abaixo é de fácil acesso, seja em lojas físicas ou online. Este processo não é dispendioso e o investimento é largamente compensado pelo resultado final. Para além dos esporos, nenhum dos itens é considerado suspeito ou restrito. Por sorte, mesmo em muitos países, as impressões de esporos de cogumelos psilocibinos não são ilegais.



1. Começa por esterilizar a água e o copo de shot/recipiente pequeno. Coloca-os numa panela de pressão e aquece até atingir os 15 psi. Assim que estiver nessa pressão, reduz a temperatura e deixa cozinhar pelo menos 30 minutos. Este tempo é fundamental para garantir que tudo fica devidamente esterilizado (se fores reutilizar seringas, podes adicioná-las nesta fase).

2. Após os 30 minutos, desliga totalmente a fonte de calor e deixa a água arrefecer até à temperatura ambiente. Esta etapa é crucial—se avançares enquanto a água ainda estiver quente, há grande risco de destruir os esporos. Não vale a pena teres todo o material esterilizado se depois acabas por inutilizar os esporos.
Normalmente, o arrefecimento completo pode demorar algumas horas, mas é mais seguro deixares de um dia para o outro. Garante que o recipiente permanece fechado! Se abrires antes do momento certo, tudo pode ficar novamente contaminado.

3. Agora estás pronto para preparar as seringas de esporos. Usa uma chama para esterilizar as pinças e o bisturi.


4. Retira o copo de shot ou recipiente pequeno da panela de pressão.

5. Utilizando as pinças, retira cuidadosamente a impressão de esporos do local de armazenamento e posiciona-a sobre a abertura do copo de shot ou recipiente pequeno.

6. Com o bisturi, raspa delicadamente alguns esporos para dentro da água esterilizada.


7. Preenche imediatamente as seringas—coloca a ponta da primeira seringa na água e enche-a. É aconselhável esvaziar a seringa novamente para o copo de shot e repetir o processo algumas vezes. Assim garantes que os esporos ficam bem distribuídos pela água—faz isto sempre que acrescentares mais esporos.

8. Depois de teres a seringa preenchida, deixa-a à temperatura ambiente durante 2 a 3 dias, para que os esporos fiquem completamente hidratados.

9. Quando os esporos estiverem hidratados, podes guardar as seringas de esporos num saco zip hermético no frigorífico. Mantêm-se viáveis até 12 meses.

Utilizar uma seringa de esporos é uma tarefa simples, desde que seja feita com cuidado. Cada seringa contém milhões de esporos e, por isso, normalmente basta aplicar cerca de 3 mililitros por cada litro quadrado de substrato. Isto corresponde a uma ou duas gotas.
Se for inocular o substrato dentro de um frasco, é provável que este tenha pequenas aberturas na tampa, tapadas com fita adesiva ou algum tampão. Independentemente do método, o procedimento é sempre igual. Perfure a fita microporosa que cobre os orifícios (ou retire o tampão) e deite uma pequena quantidade da solução de esporos sobre o substrato. A quantidade deve ser ajustada ao tamanho de cada frasco.
Depois de concluir este passo, tape novamente os orifícios com fita microporosa nova e coloque os frascos num local escuro e morno. Em princípio, ao fim de uma semana já deverá conseguir ver o micélio a desenvolver-se nos pontos onde deixou cair a solução de esporos, com um aspeto semelhante a pequenas nuvens de algodão.
Nas semanas seguintes, essas zonas brancas irão expandir-se até ocupar o frasco por completo. Não manuseie o frasco até que o micélio tenha colonizado por inteiro! Esteja também atento ao aparecimento de outros organismos, pois podem indicar contaminação.

Se forem guardadas corretamente, as seringas de esporos podem durar até 12 meses, segundo alguns relatos. Não te esqueças de que os esporos são organismos vivos e que um armazenamento inadequado pode comprometer a sua viabilidade.
Sim. As seringas de esporos devem ser sempre guardadas no frigorífico, entre 2 °C e 8 °C. Também é aconselhável mantê-las ao abrigo da luz, o que geralmente não será um problema se forem armazenadas no frigorífico.
Não. Os esporos são células que contêm água, pelo que a congelação irá destruí-los.
Sim. Se não forem devidamente armazenados, podem perder a viabilidade. Da mesma forma, mesmo bem guardados, acabam por morrer com o tempo, embora sejam surpreendentemente resistentes quando conservados nas condições ideais.
Sem dúvida. Desde que a seringa seja devidamente esterilizada e não apresente danos, pode ser reutilizada várias vezes sem problema. Para a esterilizar, encha-a com água fervida esterilizada ou coloque-a numa panela de pressão. A agulha deve ser esterilizada ao passar por uma chama.

As culturas líquidas são uma alternativa muito utilizada para inocular substratos com esporos de cogumelos. Neste método, a germinação ocorre num substrato líquido, onde se pode observar o micélio suspenso de forma difusa. Estas culturas desenvolvem-se num "caldo" nutritivo (água estéril enriquecida com açúcares).
No caso das culturas líquidas, a maioria dos cultivadores considera essencial isolar uma única estirpe, pois caso contrário poderá haver falta de controlo e uniformidade durante o cultivo, já que as diferentes estirpes irão competir entre si. Já as seringas de esporos podem conter uma única estirpe ou múltiplos esporos.
Outra forma de germinar esporos consiste em recorrer a uma solução de ágar numa placa de Petri. O ágar é um composto rico em açúcares, ideal para a germinação dos esporos e crescimento do micélio. Este método é prático, bastando colocar diretamente os esporos de uma impressão sobre a solução.
No entanto, se não for realizado dentro de uma caixa retirada de ar ou sob um fluxo laminar, existe um risco elevado de contaminação, pois a placa de Petri fica exposta, facilitando a entrada de outros microrganismos. O ambiente favorável ao desenvolvimento do micélio é também ideal para o crescimento de muitos outros organismos!
A escolha do método depende sobretudo das preferências e do nível de experiência. As seringas de esporos são geralmente a opção mais simples e recomendadas para quem está a começar. Trata-se de um processo fácil e rápido, mas a germinação no substrato é mais demorada em comparação com o uso de cultura líquida.
As culturas líquidas, apesar de serem mais complexas de preparar, costumam proporcionar melhores resultados. Neste caso, como a germinação já ocorreu e já existe micélio, a colonização do substrato é bastante mais rápida e incisiva do que por via da seringa de esporos. Isto traduz-se numa menor probabilidade de contaminação, já que o micélio parte com vantagem para dominar o ambiente. Já as seringas de esporos dão origem a uma colonização mais lenta, o que abre mais espaço ao eventual desenvolvimento de agentes concorrentes.
Tanto as seringas de esporos como as culturas líquidas podem ser adquiridas online. Contudo, é fundamental garantir a credibilidade dos vendedores e conhecer a legislação do teu país. Em algumas regiões, o micélio de cogumelos mágicos é ilegal, mesmo que os esporos não o sejam.
Se tens curiosidade em cultivar, vale a pena experimentar todos os métodos. Quando chegares à colheita das tuas primeiras levas abundantes, vais recordar com satisfação o início do processo. E, melhor ainda, já saberás como criar novas seringas com os teus próprios esporos!
Acessórios para kits de cultivo
Também lhe pode interessar
6 min
29 Julho 2024
Como conservar cogumelos mágicos
Se queres que os teus cogumelos se mantenham em boas condições durante mais tempo, não basta secá-los correctamente – é fundamental também guardá-los de forma adequada. O processo não é com ...
5 min
27 Setembro 2022
Como fazer impressões de esporos de cogumelos mágicos
Para cultivar cogumelos mágicos a partir do zero, o primeiro passo são os esporos. É a partir destes pequenos elementos que tudo se desenvolve! Fazer uma impressão de esporos em casa é bastante s ...
3 min
25 Abril 2022
O que é um frasco de esporos de cogumelos mágicos?
Pensar em começar a cultivar cogumelos mágicos? Um dos primeiros passos é encontrar esporos de qualidade. Mas surge logo uma dúvida: optar por um frasco ou por uma seringa? Aqui explicamos as vant ...
5 min
22 Abril 2021
Como preparar Lemon Tek para uma viagem de cogumelos ou trufas mais rápida
Por vezes, tudo o que queremos é uma experiência intensa e imediata. Felizmente, há uma forma de o conseguir. Se procuras viagens alucinantes em menos de vinte minutos, este é o lugar certo. Certi ...
9 min
13 Junho 2019
O que deve saber sobre cogumelos mágicos (shrooms)
Os cogumelos mágicos são valorizados pelas suas intensas propriedades psicoativas, capazes de provocar alucinações marcantes, sensações de euforia, alterações nos processos de pensamento e uma ...
6 min
20 Fevereiro 2018
Como identificar uma cultura de cogumelos mágicos contaminada
Existe uma grande variedade de contaminações à espreita. A maioria pode ser agrupada em três categorias principais: bactérias, bolores (fungos) e pragas. Vamos analisar mais de perto os tipos mai ...
Categorias
Categorias
Descubra
Informações
Ferramentas
O nosso site não funcionará corretamente sem estes cookies ativados. Por isso, os cookies funcionais não podem ser desativados.

